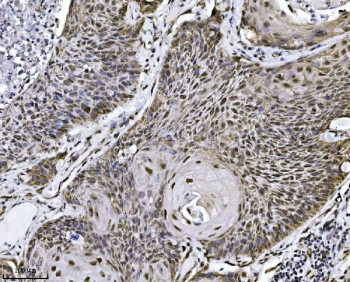
Anti-NDFIP2 / NEDD4 family-interacting protein 2, clone 10D6D7

Cookie preferences
This website uses cookies, which are necessary for the technical operation of the website and are always set. Other cookies, which increase the comfort when using this website, are used for direct advertising or to facilitate interaction with other websites and social networks, are only set with your consent.
Configuration
Technically required
These cookies are necessary for the basic functions of the shop.
"Allow all cookies" cookie
"Decline all cookies" cookie
CSRF token
Cookie preferences
Currency change
Customer-specific caching
FACT-Finder tracking
Individual prices
Selected shop
Session
Comfort functions
These cookies are used to make the shopping experience even more appealing, for example for the recognition of the visitor.
Note
Show the facebook fanpage in the right blod sidebar
Statistics & Tracking
Affiliate program
Conversion and usertracking via Google Tag Manager
Track device being used
| Item number | Size | Datasheet | Manual | SDS | Delivery time | Quantity | Price |
|---|---|---|---|---|---|---|---|
| NSJ-RQ7112 | 100 µg | - | - |
3 - 10 business days* |
790.00€
|
If you have any questions, please use our Contact Form.
You can also order by e-mail: info@biomol.com
Larger quantity required? Request bulk
You can also order by e-mail: info@biomol.com
Larger quantity required? Request bulk
0.5mg/ml if reconstituted with 0.2ml sterile DI water. NEDD4 family-interacting protein 2 is a... more
Product information "Anti-NDFIP2 / NEDD4 family-interacting protein 2, clone 10D6D7"
0.5mg/ml if reconstituted with 0.2ml sterile DI water. NEDD4 family-interacting protein 2 is a protein that in humans is encoded by the NDFIP2 gene. The NEDD4 family-interacting protein 1 (NDFIP1) belongs to a small group of evolutionarily conserved proteins with three transmembrane domains and is an integral Golgi membrane protein. It is a potential target for ubiquitination by the Nedd4 family of proteins. NDFIP1 is strongly expressed in surviving neurons following acute cortical brain injury, and overexpression in cultured cortical neurons increased survival following growth factor starvation, suggesting that NDFIP1 may play a role in neuronal survival. NDFIP1 and the related protein NDFIP2 are thought to interact with and regulate multiple components of the EGF and PTEN/Akt signaling pathways. Recent studies suggest that NDFIP1 may also play a role in Th17 differentiation by limiting the production of proinflammatory cytokines. Protein function: Activates HECT domain-containing E3 ubiquitin-protein ligases, including ITCH, NEDD4, NEDD4L, SMURF2, WWP1 and WWP2, and consequently modulates the stability of their targets. As a result, may control many cellular processes. Recruits ITCH, NEDD4 and SMURF2 to endosomal membranes. Negatively regulates KCNH2 potassium channel activity by decreasing its cell-surface expression and interfering with channel maturation through recruitment of NEDD4L to the Golgi apparatus and multivesicular body where it mediates KCNH2 degradation (PubMed:26363003). May modulate EGFR signaling. Together with NDFIP1, limits the cytokine signaling and expansion of effector Th2 T-cells by promoting degradation of JAK1, probably by ITCH- and NEDD4L-mediated ubiquitination. [The UniProt Consortium]
| Keywords: | Anti-NDFIP2, Anti-KIAA1165, Anti-NEDD4 WW domain-binding protein 5A, Anti-NEDD4 family-interacting protein 2, Anti-Putative NF-kappa-B-activating protein 413, Anti-Putative MAPK-activating protein PM04/PM05/PM06/PM07, NDFIP2 Antibody / NEDD4 family-intera |
| Supplier: | NSJ Bioreagents |
| Supplier-Nr: | RQ7112 |
Properties
| Application: | WB, IHC (paraffin), IF, FC |
| Antibody Type: | Monoclonal |
| Clone: | 10D6D7 |
| Conjugate: | No |
| Host: | Mouse |
| Species reactivity: | human |
| Immunogen: | Recombinant human protein (amino acids M16-L336) |
| Format: | Posttranslational Mod. |
Database Information
| KEGG ID : | K25839 | Matching products |
| UniProt ID : | Q9NV92 | Matching products |
| Gene ID : | GeneID 54602 | Matching products |
Handling & Safety
| Storage: | +4°C |
| Shipping: | +4°C (International: +4°C) |
Caution
Our products are for laboratory research use only: Not for administration to humans!
Our products are for laboratory research use only: Not for administration to humans!
Information about the product reference will follow.
more
You will get a certificate here
Viewed